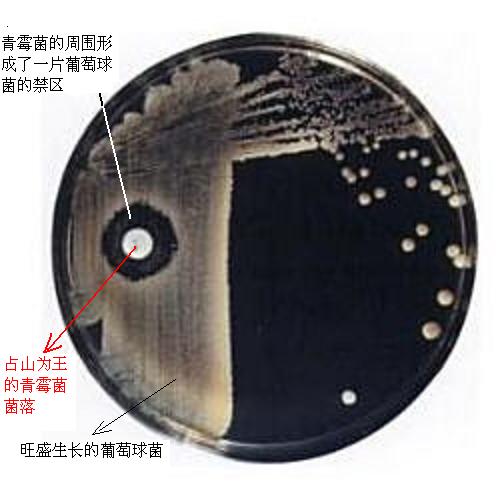
���Ǿ��� ������

菌城旧事 (二)
菌城旧事(二),青霉素的长剧,磺胺的寓言,细菌
![]() |
![]() |
![]() |
![]() |
![]() |
![]() |
![]() |
| 青霉素分子 |
![]() |
![]() |
| 青霉素菌株 |
![]() |
细菌从混沌中来,小心翼翼如履薄冰。古菌、噬菌体、真菌、植物、动物陆陆续续地出现,生命之树抽枝发芽枝繁叶茂,把这个星球装点得像一个生机盎然的乐园。实际上,这个万类霜天竞自由的生命舞台,更像是一个万物殊死搏杀的修罗场;生命之树枝叶间繁花似锦,都是物种间白热斗争的硝烟。和其它生物一样,人类甫一出现,就面临着细菌的考验。人类最晚加入这场争夺生存空间的斗争,在几千年的时间里,从简单的观察自然中,渐渐找到了一种截然不同的斗争方式。
青霉素的长剧
人类对抗细菌的最早尝试,可能又是来自古代中国。尽管不知道什么导致着伤口的溃烂,也不知道发霉是怎么回事,两千五百多年前的古代中国人就意识到“霉”能帮助伤口顺利愈合。其实为了避免伤口的腐溃,人们曾用过各种各样的方法,比如敷用矿物,或者一些稀奇古怪的植物,甚至动物的粪便。在漫长的摸索过程中,人们隐约觉得这个看似混乱的世界,好像存在着一种相互约束相互拮抗的秩序。
青霉素菌株
自然界用隐晦的方式向人类提示着她的秘密。无数的探索者日以继夜地研究,希望能找到征服感染疾病的方法。尽管直到二十世纪,基于列文虎克(Antonie van Leeuwenhoek)、罗伯特·科赫(Robert Koch)以及路易斯·巴斯德(Louis Pasteur)的伟大成就,人们才认清感染的元凶是各种各样的细菌,但是历史上无数的先行者从以往的不断尝试中受到启发,早就开始打霉菌的主意了。他们中不少人其实已经触到了答案,却茫茫然失之交臂。1875年,英国细菌学家约翰·泰达尔(John Tyndall)就在研究细菌的时候发现青霉菌能控制其他细菌的生长,并公开发表了他的研究成果。在他之后,至少有七位科学家也获得了类似的发现,而在他之前,记载的类似发现更是不胜枚举。可惜,他们的发现,甚至没能让饱受细菌摧残的世界感受到一丝希望。也许是因为人类在阴影下生活得太久了,细菌带来的死亡和伤痛已经让我们变得麻木而绝望。人们甚至悲观地认为,“抗菌药物是幻影(Antibacterial drugs are a delusion)”。
黎明前的困境一直持续到1928年9月28日,一个普通的星期五。
苏格兰的细菌学家弗莱明一直在研究威胁人类健康的葡萄球菌,就在这个早上,他偶然注意到培养皿中一簇不期而至的霉菌周围,似乎有一个禁区,原本生长旺盛的金黄色葡萄球菌不敢越雷池半步。这个现象深深吸引了弗莱明。他发现这种叫做青霉菌的真菌能杀死所有靠近它们的葡萄球菌,经过反复试验,证实是青霉菌分泌出的某类化学物质——虽然还不知道究竟是些什么 ......
您现在查看是摘要页,全文长 11389 字符。